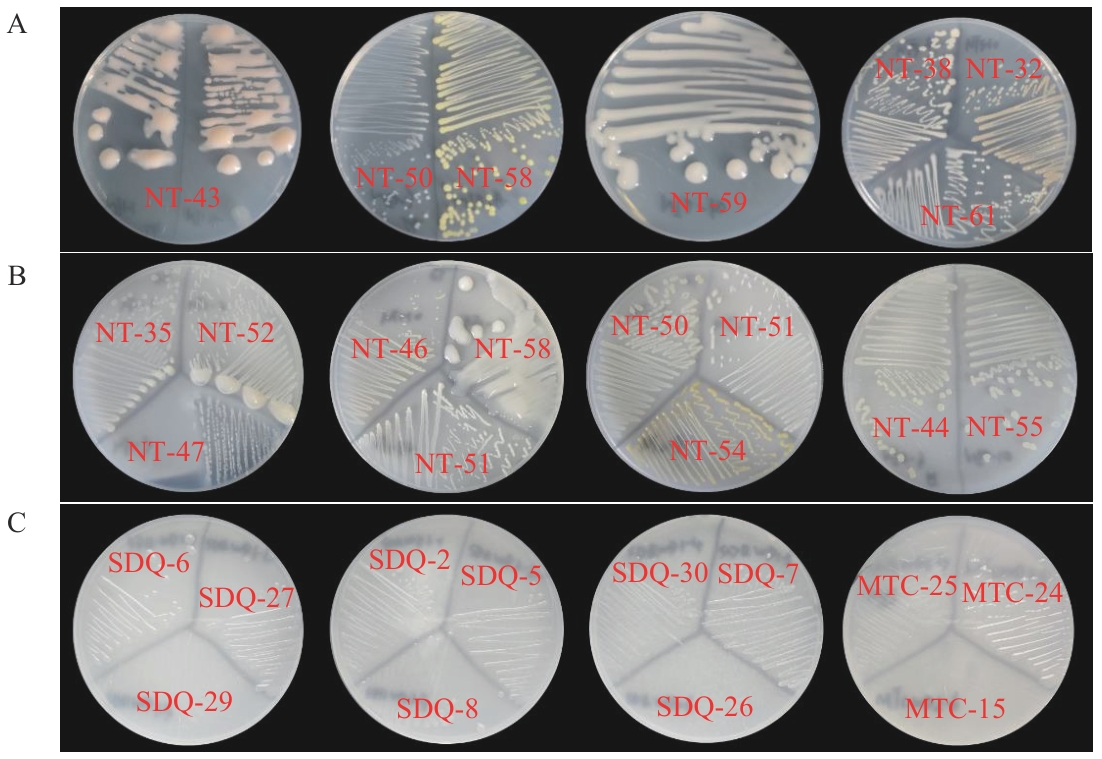

Biotechnology Bulletin ›› 2025, Vol. 41 ›› Issue (6): 317-326.doi: 10.13560/j.cnki.biotech.bull.1985.2024-1242
ZHANG Jun-jie( ), LIU Shuang, HU Ming-zhu, SHI Xue-rui, DAI Jin-xia(
), LIU Shuang, HU Ming-zhu, SHI Xue-rui, DAI Jin-xia( )
)
Received:2024-12-23
Online:2025-06-26
Published:2025-06-30
Contact:
DAI Jin-xia
E-mail:2293311278@qq.com;daijx05@163.com
ZHANG Jun-jie, LIU Shuang, HU Ming-zhu, SHI Xue-rui, DAI Jin-xia. Screening of Nitrogen-fixing Microorganisms in Rhizosphere Soil of Desert Plants and Their Stress-resistant and Growth-promoting Characteristics[J]. Biotechnology Bulletin, 2025, 41(6): 317-326.
土壤样品 Soil sample | 联合固氮培养基 Combined nitrogen-fixing culture medium | 固氮类芽胞杆菌培养基 Nitrogen-fixing Bacillus culture medium | 无氮培养基 Nitrogen-free culture medium | nifH基因阳性菌株 nifH gene-positive strain |
|---|---|---|---|---|
| NT | 23 | 12 | 9 | 31 |
| SDQ | 12 | 15 | 9 | 13 |
| MTC | 12 | 9 | 12 | 13 |
| MC | 11 | 9 | 11 | 4 |
Table 1 Screening results of nitrogen-fixing bacterial strains
土壤样品 Soil sample | 联合固氮培养基 Combined nitrogen-fixing culture medium | 固氮类芽胞杆菌培养基 Nitrogen-fixing Bacillus culture medium | 无氮培养基 Nitrogen-free culture medium | nifH基因阳性菌株 nifH gene-positive strain |
|---|---|---|---|---|
| NT | 23 | 12 | 9 | 31 |
| SDQ | 12 | 15 | 9 | 13 |
| MTC | 12 | 9 | 12 | 13 |
| MC | 11 | 9 | 11 | 4 |
Fig. 1 Colony morphology of some nitrogen-fixing strainsA: Combined nitrogen-fixing culture medium. B: Nitrogen-fixing Bacillus culture medium. C: Nitrogen-free culture medium
培养条件 Cultivation conditions | 正常生长菌数 Normal growth count | |
|---|---|---|
| NaCl | 3% | 61 |
| 5% | 52 | |
| 7% | 35 | |
| 9% | 13 | |
| PEG6000 | 15% | 52 |
| 25% | 18 | |
| 35% | 13 | |
| pH | 9 | 61 |
| 10 | 61 | |
| 11 | 33 | |
| 12 | 4 | |
Table2 Screening results of strain stress resistance
培养条件 Cultivation conditions | 正常生长菌数 Normal growth count | |
|---|---|---|
| NaCl | 3% | 61 |
| 5% | 52 | |
| 7% | 35 | |
| 9% | 13 | |
| PEG6000 | 15% | 52 |
| 25% | 18 | |
| 35% | 13 | |
| pH | 9 | 61 |
| 10 | 61 | |
| 11 | 33 | |
| 12 | 4 | |

Fig. 3 Growth-promoting activities of some strainsThe lowercase letters in the figure indicate significant difference in growth-promoting ability among different strains (P<0.05).There are 3 replicates in each experiment, the same below

Fig. 4 Growth of potted alfalfa under different treatmentsCK: The uninoculated control group; D1 and D2: single inoculation groups of SDQ-1and MC-20, respectively; F: the compound inoculation group

Fig. 5 Root-related indexes of alfalfa under different treatmentsCK: Control group root scanning data; D1, D2: the root scan data for the SDQ-1 and MC-20 single inoculant groups were obtained; F: root scanning data of the composite inoculation group. the same below
| 1 | Naqqash T, Imran A, Hameed S, et al. First report of diazotrophic Brevundimonas spp. as growth enhancer and root colonizer of potato [J]. Sci Rep, 2020, 10(1): 12893. |
| 2 | 韩风毅, 张贻荣, 王思荣, 等. 亚热带典型杉木人工林根际土壤固氮菌丰度和群落结构 [J]. 应用生态学报, 2024, 35(6): 1681-1688. |
| Han FY, Zhang YR, Wang SR, et al. Abundance and community structure of nitrogen-fixing bacteria in rhizosphere soil of typical Chinese fir plantation in subtropical zone [J]. China Ind Econ, 2024, 35(6): 1681-1688. | |
| 3 | 王晓菲, 罗珠珠, 李玲玲, 等. 黄土高原不同种植年限苜蓿土壤固氮微生物群落结构和丰度特征 [J]. 中国生态农业学报: 中英文, 2023, 31(5): 665-676. |
| Wang XF, Luo ZZ, Li LL, et al. Characteristics of structure and abundance of soil nitrogen-fixing bacterial community in alfalfa with different growing ages in the Loess Plateau [J]. Chin J Eco Agric, 2023, 31(5): 665-676. | |
| 4 | Ben Romdhane S, De Lajudie P, Fuhrmann JJ, et al. Potential role of rhizobia to enhance chickpea-growth and yield in low fertility-soils of Tunisia [J]. Antonie Van Leeuwenhoek, 2022, 115(7): 921-932. |
| 5 | 陈海荣, 刘欢, 伍善东, 等. 一株花生根瘤菌高效菌株的筛选及其在原生环境中的应用 [J]. 激光生物学报, 2025, 34(1): 45-53, 62. |
| Chen HR, Liu H, Wu SD, et al. Screening of an efficient peanut Rhizobium strain and its application in primary environment [J]. Acta Laser Biol Sin, 2025, 34(1): 45-53, 62. | |
| 6 | 宋维民, 王丽艳, 郭永霞, 等. 秸秆还田条件下固氮蓝藻复合菌剂与促生细菌SM13对水稻产量及稻米品质的影响 [J]. 南方农业学报, 2021, 52(3): 762-768. |
| Song WM, Wang LY, Guo YX, et al. Effects of nitrogen-fixing cyanobacteria complex microbial inoculant and growth-promoting bacteria SM13 on yield and quality of rice with straw turnover [J]. J South Agric, 2021, 52(3): 762-768. | |
| 7 | Zhang W, Bahadur A, Sajjad W, et al. Bacterial diversity and community composition distribution in cold-desert habitats of Qinghai-Tibet Plateau, China [J]. Microorganisms, 2021, 9(2): 262. |
| 8 | 王卫霞. 新疆几种典型荒漠植物根际微生物特征及内生固氮菌的分离、促生性能研究 [D]. 乌鲁木齐: 新疆农业大学, 2009. |
| Wang WX. Characteristics of rhizosphere microorganisms of several typical desert plants in Xinjiang and isolation and growth-promoting performance of endophytic nitrogen-fixing bacteria [D]. Urumqi: Xinjiang Agricultural University, 2009. | |
| 9 | Timmusk S, Abd El-Daim IA, Copolovici L, et al. Drought-tolerance of wheat improved by rhizosphere bacteria from harsh environments: enhanced biomass production and reduced emissions of stress volatiles [J]. PLoS One, 2014, 9(5): e96086. |
| 10 | Ullah S, Bano A. Isolation of plant-growth-promoting rhizobacteria from rhizospheric soil of halophytes and their impact on maize (Zea mays L.) under induced soil salinity [J]. Can J Microbiol, 2015, 61(4): 307-313. |
| 11 | 陈伟立, 李娟, 朱红惠, 等. 根际微生物调控植物根系构型研究进展 [J]. 生态学报, 2016, 36(17): 5285-5297. |
| Chen WL, Li J, Zhu HH, et al. A review of the regulation of plant root system architecture by rhizosphere microorganisms [J]. Acta Ecol Sin, 2016, 36(17): 5285-5297. | |
| 12 | Teng Y, Wang XM, Li LN, et al. Rhizobia and their bio-partners as novel drivers for functional remediation in contaminated soils [J]. Front Plant Sci, 2015, 6: 32. |
| 13 | 杨鸿儒, 袁博, 赵霞, 等. 三种荒漠灌木根际可培养固氮细菌类群及其固氮和产铁载体能力 [J]. 微生物学通报, 2016, 43(11): 2366-2373. |
| Yang HR, Yuan B, Zhao X, et al. Cultivable diazotrophic community in the rhizosphere of three desert shrubs and their nitrogen-fixation and siderophore-producing capabilities [J]. Microbiol China, 2016, 43(11): 2366-2373. | |
| 14 | 刘爽, 姚佳妮, 沈聪, 等. 荒漠植物柠条根际土壤nifH基因荧光定量及固氮菌多样性分析 [J]. 生物技术通报, 2022, 38(12): 252-262. |
| Liu S, Yao JN, Shen C, et al. Fluorescent quantitative PCR of nifH gene and diversity analysis of nitrogen-fixing bacteria in the rhizosphere soil of Caragana spp. of desert grassland [J]. Biotechnol Bull, 2022, 38(12): 252-262. | |
| 15 | 代金霞, 周波, 田平雅. 荒漠植物柠条产ACC脱氨酶根际促生菌的筛选及其促生特性研究 [J]. 生态环境学报, 2017, 26(3): 386-391. |
| Dai JX, Zhou B, Tian PY. Screening and growth-promoting effects of rhizobacteria with ACC deaminase activity from rhizosphere soil of Caragana korshinskii grown in desert grassland [J]. Ecol Environ Sci, 2017, 26(3): 386-391. | |
| 16 | 杜艺, 周波, 袁娜娜, 等. 荒漠植物根际解磷细菌的筛选及抑菌和促生特性研究 [J]. 农业科学研究, 2024, 45(1): 20-25. |
| Du Y, Zhou B, Yuan NN, et al. Screening of phosphate-solubilizing bacteria in rhizosphere of desert plants and their antibacterial and growth-promoting effects [J]. J Agric Sci, 2024, 45(1): 20-25. | |
| 17 | 东秀珠, 蔡妙英. 常见细菌系统鉴定手册 [M]. 北京: 科学出版社, 2001. |
| Dong XZ, Cai MY. Handbook of identification of common bacterial systems [M]. Beijing: Science Press, 2001. | |
| 18 | 布坎南, 中国科学院微生物研究所. 伯杰氏细菌鉴定手册[M]. 第8版, 北京: 科学出版社, 1984. |
| Buchanan, Institute of Microbiology, Chinese Academy of Sciences. Bergey's manual of determinative bacteriology[M]. 8th ed., Beijing: Science Press, 1984. | |
| 19 | 郭振华. 阿尔山地区白桦和落叶松根际土壤固氮菌初步研究 [D]. 呼和浩特: 内蒙古农业大学, 2019. |
| Guo ZH. Preliminary study on nitrogen-fixing bacteria in rhizosphere soil of Betula platyphylla and Larix gmelinii in Aershan area [D]. Hohhot: Inner Mongolia Agricultural University, 2019. | |
| 20 | 张胜男, 杨杉杉, 高海燕, 等. 沙蓬(Agriophyllum squarrosum)根际固氮菌群落结构特征 [J]. 中国沙漠, 2024, 44(4): 174-183. |
| Zhang SN, Yang SS, Gao HY, et al. Dynamic characteristics of diazotrophs community in the rhizosphere of Agriophyllum squarrosum [J]. J Desert Res, 2024, 44(4): 174-183. | |
| 21 | Mubeen M, Bano A, Ali B, et al. Effect of plant growth promoting bacteria and drought on spring maize (Zea mays L.) [J]. Pak J Bot, 2021, 53(2): 731-739. |
| 22 | 曹晶晶, 熊悯梓, 钞亚鹏, 等. 极耐盐碱固氮菌的分离鉴定及固氮特性研究 [J]. 微生物学报, 2021, 61(11): 3483-3495. |
| Cao JJ, Xiong MZ, Chao YP, et al. Isolation and identification of extremely salt-tolerant Azotobacter and its nitrogen-fixing characteristics [J]. Acta Microbiol Sin, 2021, 61(11): 3483-3495. | |
| 23 | 沈聪, 刘爽, 苏建宇, 等. 半干旱荒漠区柠条根际细菌群落结构与功能 [J]. 基因组学与应用生物学, 2021, 40(Z4): 3508-3517. |
| Shen C, Liu S, Su JY, et al. Rhizosphere bacterial community structure and function of Caragana korshinskii in semiarid desert area [J]. Genomics and Applied Biology, 2021, 40(Z4): 3508-3517. | |
| 24 | Ashry NM, Alaidaroos BA, Mohamed SA, et al. Utilization of drought-tolerant bacterial strains isolated from harsh soils as a plant growth-promoting rhizobacteria (PGPR) [J]. Saudi J Biol Sci, 2022, 29(3): 1760-1769. |
| 25 | Gadhave KR, Devlin PF, Ebertz A, et al. Soil inoculation with Bacillus spp. modifies root endophytic bacterial diversity, evenness, and community composition in a context-specific manner [J]. Microb Ecol, 2018, 76(3): 741-750. |
| 26 | Ahmed B, Shahid M, Syed A, et al. Drought tolerant Enterobacter sp./Leclercia adecarboxylata secretes indole-3-acetic acid and other biomolecules and enhances the biological attributes of Vigna radiata (L.) R. Wilczek in water deficit conditions [J]. Biology, 2021, 10(11): 1149. |
| 27 | 徐太海, 齐传伟, 靳晓晨, 等. 耐盐碱细菌筛选及与发酵尾液肥料的配施应用研究 [J]. 环境科学与管理, 2022, 47(9): 143-147. |
| Xu TH, Qi CW, Jin XC, et al. Screening of saline alkali tolerant bacteria and its combined application with fermentation tail liquor fertilizer [J]. Environ Sci Manag, 2022, 47(9): 143-147. | |
| 28 | 王佳玮, 谭澳平, 刘建利, 等. 荒漠植物根际促生菌的筛选及其对青贮玉米幼苗的促生效应 [J]. 干旱地区农业研究, 2024, 42(2): 210-221. |
| Wang JW, Tan AP, Liu JL, et al. Screening of rhizosphere growth-promoting bacteria of desert plants and its promoting effects on silage maize seedlings [J]. Agric Res Arid Areas, 2024, 42(2): 210-221. | |
| 29 | 李显刚, 姚拓, 王小利, 等. 一株分离自葛藤根际高效溶磷细菌特性研究及菌株鉴定 [J]. 中国土壤与肥料, 2012(2): 87-91. |
| Li XG, Yao T, Wang XL, et al. Characteristics and identification of a dissolving phosphate bacteria strain isolated from rhizosphere of Puerarialobata [J]. Soil Fertil Sci China, 2012(2): 87-91. | |
| 30 | Tiwari G, Duraivadivel P, Sharma S, et al. 1-Aminocyclopropane-1-carboxylic acid deaminase producing beneficial rhizobacteria ameliorate the biomass characters of Panicum maximum Jacq. by mitigating drought and salt stress [J]. Sci Rep, 2018, 8(1): 17513. |
| 31 | 杨红军, 王浩洋, 崔庆华, 等. 盐胁迫下盐地碱蓬根系分泌物中化合物的种类和含量研究 [J]. 湿地科学, 2023, 21(5): 663-670. |
| Yang HJ, Wang HY, Cui QH, et al. Components and contents of compounds in root exudates of Suaeda salsa under salt stress [J]. Wetl Sci, 2023, 21(5): 663-670. | |
| 32 | 韩文星, 姚拓, 梁启鹏, 等. PGPR菌肥对燕麦根系性状影响的研究 [J]. 草原与草坪, 2008, 28(4): 1-4. |
| Han WX, Yao T, Liang QP, et al. Effect of PGPR biofertilizer on root traits of Oat [J]. Grassland Turf, 2008, 28(4): 1-4. | |
| 33 | 闫增林. 耐盐促生细菌的筛选及其对小麦生长的影响 [D]. 泰安: 山东农业大学, 2019. |
| Yan ZL. Screening of salt-tolerant growth-promoting bacteria and its effect on wheat growth [D]. Tai'an: Shandong Agricultural University, 2019. |
| [1] | DUAN Yong-hong, YANG Xin, YU Guan-qun, XIA Jun-jun, SONG Lu-shuai, BAI Xiao-dong, PENG Suo-tang. Genetic Diversity and Principal Component Analysis of 125 Potato Germplasm Resources [J]. Biotechnology Bulletin, 2025, 41(6): 130-143. |
| [2] | ZHOU Qian, TANG Meng-jun, ZHANG Xiao-yan, LU Jun-xian, TANG Xiu-jun, YANG Xing-xing, GAO Yu-shi. Research Progress in the Control of Multidrug Resistant Bacteria Based on in CRISPR-Cas System [J]. Biotechnology Bulletin, 2025, 41(5): 42-51. |
| [3] | LI Wen-lan, HOU Xin-wei, LI Yan, ZHAO Rui-jun, MENG Zhao-dong, YUE Run-qing. Identification and Resistance Detection of Homozygous and Heterozygous Plants of Transgenic Maize LD05 with Resistances to Insect and Herbicide [J]. Biotechnology Bulletin, 2025, 41(4): 123-133. |
| [4] | SONG Jia-yi, SU Yun-li, ZHENG Xing-yan, XIA Wen-nian, YANG Dong-mei, HU Hui-zhen. Identification of the Snapdragon Expansin Gene Family and Screening of Its Genes Related to Resistance to Sclerotinia sclerotiorum [J]. Biotechnology Bulletin, 2025, 41(4): 227-242. |
| [5] | TONG De-li, ZHANG Xin, CHEN Jia-qing, HE Hai-sheng. Isolation of Endophytic Bacteria from Blueberry and Its Alleviative Effects on Brassica chinensis L. under Aluminum Stress [J]. Biotechnology Bulletin, 2025, 41(4): 302-311. |
| [6] | TIAN Qin, LIU Kui, WU Xiang-wei, JI Yuan-yuan, CAO Yi-bo, ZHANG Ling-yun. Functional Study of Transcription Factor VcMYB17 in Regulating Drought Tolerance in Blueberry [J]. Biotechnology Bulletin, 2025, 41(4): 198-210. |
| [7] | WANG Bin, LIN Wei, XIAO Yan-hui, YUAN Xiao. Research Progress in the Roles of Plant Glycine-rich Protein Family [J]. Biotechnology Bulletin, 2025, 41(2): 1-17. |
| [8] | MA Tian-yi, XU Jia-jia, LU Wen-jing, WU Yan, SHA Wei, ZHANG Mei-juan, PENG Yi-fang. Expression Analysis and Resistance Identification of BrcGASA3 in Chinese Cabbage ‘Jinxiaotong’ Cultivar under Saline-alkali Stress [J]. Biotechnology Bulletin, 2025, 41(2): 127-138. |
| [9] | YU Jing, YU Gui-shuang, SUN Hao-jie, JIANG Chun-jiao, YUAN Guang-di, YANG Zhen, WANG Zhi-wei, WANG Chao, WANG Chuan-tang. Affecting Factors and Relevant Marker Study on Peanut Seed Quality [J]. Biotechnology Bulletin, 2025, 41(2): 284-294. |
| [10] | HE Han, LIU Chuan-he, YU Meng-fan, YUAN Meng-ping, WEI Yue-rong, YANG Min, KUANG Rui-bin, ZHOU Chen-ping, WU Xia-ming, XU Ze. Development of Insertion-deletion Markers in Ananas comosus of Genome Based on Re-sequencing Data [J]. Biotechnology Bulletin, 2025, 41(2): 65-76. |
| [11] | SONG Ying-pei, WANG Can, ZHOU Hui-wen, KONG Ke-ke, XU Meng-ge, WANG Rui-kai. Analysis of Soybean Pod Dehiscence Habit Based on Whole Genome Association Analysis and Genetic Diversity [J]. Biotechnology Bulletin, 2025, 41(2): 97-106. |
| [12] | MAO Xiang-hong, LU Yao, FAN Xiang-bin, DU Pei-bing, BAI Xiao-dong. Genetic Diversity Analysis of Potato Varieties Based on SSR Fluorescent Marker Capillary Electrophoresis and Construction of Molecular Identity Card [J]. Biotechnology Bulletin, 2024, 40(9): 131-140. |
| [13] | WANG Mei-ling, GENG Li-li, FANG Yu, SHU Chang-long, ZHANG Jie. Control Potential of Bacillus thuringiensis 4BM1 Strain to Sclerotiniose in Brassica campestris L. [J]. Biotechnology Bulletin, 2024, 40(9): 260-269. |
| [14] | WANG Ke-ran, YAN Jun-jie, LIU Jian-feng, GAO Yu-lin. Application and Risk of RNAi Technology in Potato Insect Pest Management [J]. Biotechnology Bulletin, 2024, 40(9): 4-10. |
| [15] | ZHAO Ping-juan, LIN Chen-yu, WANG Meng-yue, ZHANG Xiu-chun, LI Shu-xia, RUAN Meng-bin. Sequence Analysis of MeSDH Protein and Its Relationship with MeH1.2 in Cassava [J]. Biotechnology Bulletin, 2024, 40(9): 74-81. |
| Viewed | ||||||
|
Full text |
|
|||||
|
Abstract |
|
|||||